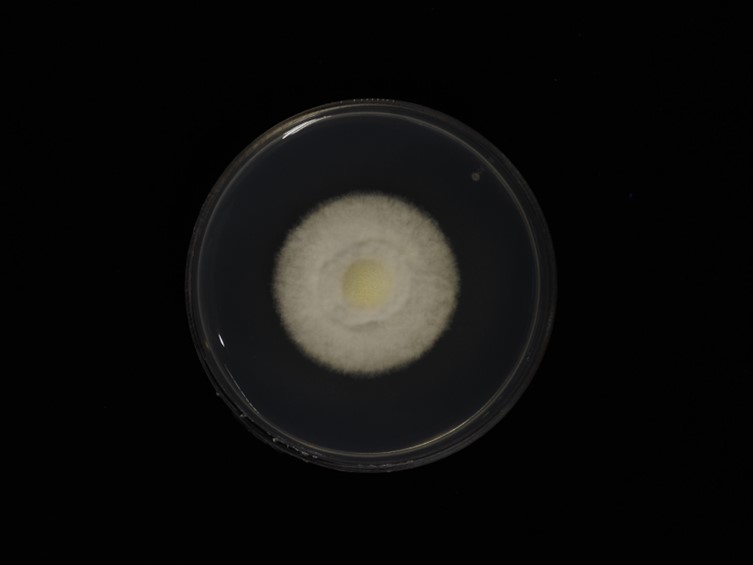

Holotype:
THAILAND, Phetchabun Province, Nam Nao National Park, 24 Nov. 2016, K. Tasanathai, S. Mongkolsamrit, R. Promharn, holotype BBH 42364, ex-type living culture TBRC 7244.
Habitat:
Stem of dicotyledonous plant.
Host:
Spider (Araneae).
Description:
On a spider host (Araneae).  Synnemata are up to 1.5 mm long, up to 400 μm wide, covered by dense white to cream mycelia bearing numerous conidiophores with powdery
Synnemata are up to 1.5 mm long, up to 400 μm wide, covered by dense white to cream mycelia bearing numerous conidiophores with powdery  conidia. Conidiophores loosely grouped together, arising from different parts of the spider, usually biverticillate with
conidia. Conidiophores loosely grouped together, arising from different parts of the spider, usually biverticillate with  phialides in whorls of two to five. Phialides 7–12 × 2–3 μm, with a cylindrical to ellipsoidal basal portion, tapering into a distinct neck, 1–5 × 1–1.5 μm. Conidia in chains, hyaline, mostly fusiform or lemon-shaped, 1-celled, 2–4 × 1–2 μm.
phialides in whorls of two to five. Phialides 7–12 × 2–3 μm, with a cylindrical to ellipsoidal basal portion, tapering into a distinct neck, 1–5 × 1–1.5 μm. Conidia in chains, hyaline, mostly fusiform or lemon-shaped, 1-celled, 2–4 × 1–2 μm.
Culture characteristics:
Colony on PDA moderately fast-growing, ca 3 cm diam in 14 d at 25 °C, white, turning pale yellow in the center within 14 d, cottony with high mycelial density, reverse pale yellow. Prostrate hyphae smooth, septate, hyaline, 2–3 μm diam. Conidiophores mostly erect, arising from prostrate hyphae, sometimes found on aerial hyphae, verticillate with phialides in whorls of two to five or occasionally with solitary phialides along the hyphae. Phialides 8–15 × 2–3 μm, with cylindrical basal portion, tapering into a long neck, 2–7 × 1–1.5 μm. Conidia in chains, hyaline, cylindrical to ellipsoidal, 1-celled, 2–5 × 1.5–3 μm. Chlamydospores and synnemata not observed.
Colony on PDA moderately fast-growing, ca 3 cm diam in 14 d at 25 °C, white, turning pale yellow in the center within 14 d, cottony with high mycelial density, reverse pale yellow. Prostrate hyphae smooth, septate, hyaline, 2–3 μm diam. Conidiophores mostly erect, arising from prostrate hyphae, sometimes found on aerial hyphae, verticillate with phialides in whorls of two to five or occasionally with solitary phialides along the hyphae. Phialides 8–15 × 2–3 μm, with cylindrical basal portion, tapering into a long neck, 2–7 × 1–1.5 μm. Conidia in chains, hyaline, cylindrical to ellipsoidal, 1-celled, 2–5 × 1.5–3 μm. Chlamydospores and synnemata not observed.
Reference:
A. Khonsanit, D. Thanakitpipattana, S. Mongkolsamrit, et al. (2024). A phylogenetic assessment of Akanthomyces sensu lato in Cordycipitaceae (Hypocreales, Sordariomycetes): introduction of new genera, and the resurrection of Lecanicillium. Fungal Systematics and Evolution14:271–305.
DOI: https://doi.org/10.3114/fuse.2024.14.17Species |
Strain |
Compound |
Pubchem CID |
Biological activity |
Reference |
|---|
|
Strain |
MF140751 | MF140752 |
|---|---|---|
| TBRC 7242 | - | - |
| TBRC 7244 | - | - |